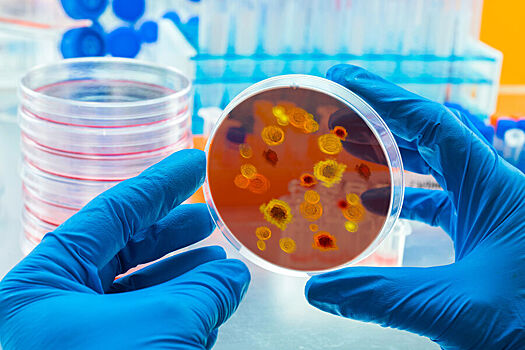
РЕН ТВ: в&nbsp;КНР распространяется вызывающий бронхит и&nbsp;воспаление легких пневмовирус

В КНР распространяется вызывающий бронхит и воспаление легких пневмовирус. Об этом сообщил «РЕН ТВ» инфекционист Георгий Викулов.
Сообщается, что этот вирус был открыт в 2000 году и не нов. Однако его нынешнее массовое распространение в Китае, по словам Викулова, может повлиять на эпидемиологическую ситуацию в РФ и странах Евросоюза.
Подчеркивается, что иммунопрофилактики для этого вируса не существует, однако у него мало штаммов.
«В России уже есть некоторые препараты, обладающие широким противовирусным действием и способные помочь борьбе с метапневмовирусом», — отметил Викулов.
До этого россиян предупредили, что доминирующий в стране вирус способен вызвать пневмонию за сутки. Почти у всех заболевших поднимается температура, появляются кашель и насморк, у каждого второго — головные боли и боль в горле.
Ранее было раскрыто эволюционное происхождение вируса гепатита.